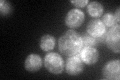
YML067C
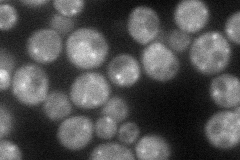
YML067C
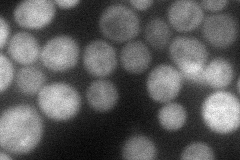
YML067C
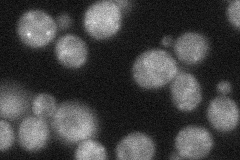
YML067C
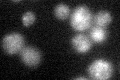
YML067C

View description
Protein localized to COPII-coated vesicles, forms a complex with Erv46p; involved in the membrane fusion stage of transport; has homology to human ERGIC2 (PTX1) protein
Localization:
Intensity:
Fold change:
Significance:
-
C’ GFP library in SD
punctate:ER43.58 -
N' NOP1pr-GFP in SD
cytosol,punctate62.6946 -
N' TEF2pr-mCherry in SD
cytosol56.8516 -
N' NATIVEpr-GFP in SD
punctate35.6028 -
N' TEF2pr-VC and Cyto-VN in SD

below threshold24.6731 -
C’ GFP library in SD+DTT

punctate.ER27.180.62Yes -
C’ GFP library in SD+H2O2

punctate.ER41.10.94No -
C’ GFP library in Starvation Media
punctate,ER40.560.93No -
C’ GFP library on the background of Pup2-DaMP

punctate:ER -
C’ GFP library on the background of CCT mutant

punctate:ER40.82650.936586No
